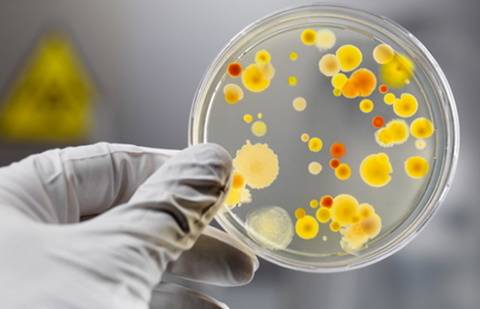
Фото с сайта old.rk

"Департаментом по защите прав потребителей города Астаны на постоянной основе ведётся мониторинг за пищевой безопасностью города. По вопросу соблюдения санитарных требований, заключения производственного контроля департаментом проведены круглые столы, лекции, беседы и семинары", - сказал Нурлыбек Асылбеков.
Он сообщил, что с начала года количество носителей патогенной микрофлоры увеличилось.
"На сегодня лабораторно обследовано на носителей патогенной микрофлоры около восьми тысяч человек из декретированной группы населения (лица, работающие в сфере обслуживания, представляющие наибольшую опасность для заражения окружающих инфекционными и паразитарными заболеваниями. - Авт.). Это повара, кухрабочие, официанты и так далее. Выявлено 9 носителей сальмонеллёзной инфекции. Для сравнения, в 2014 году было обследовано более 23 тысяч человек и выявлено всего два носителя данной инфекции. Как видите рост носителей сальмонеллёзной инфекции за эти пять месяцев - более чем в четыре раза", - уточнил он.
По его словам, причиной роста является заражённая продукция. Он отметил, что с марта по май этого года проведён отбор 165 проб продукции из объектов торговли и общественного питания.
"Выявлено несоответствие в 55 пробах по несоблюдению технического регламента и микробиологическим показателям. В том числе, из исследованных 58 проб птицепродукции в 24 пробах продукции, отобранной в торговой сети города, выделена сальмонелла. Это составляет 41%. Продукция из России, Украины, Казахстана. В 2014 году было выявлено всего в 6% опасной птицепродукции. Если сравнить 41% и 6%, рост идёт в семь раз. Помимо этого обнаруживается сальмонелла в готовой продукции: котлеты, баранина, морской гребешок. Что свидетельствует о вторичном обсеменении", - остановился на результатах проведённой работы Асылбеков.
Он добавил, что на сегодняшний день департаментом снято с реализации более 1300 кг мяса птицы, в том числе, уничтожено 750 кг продукции, заражённой сальмонеллой. 550 кг продукции возвращено производителю.
"В целях предупреждения случаев пищевых отравлений за истекший период обеспечен охват контролем всех объектов питания в медицинских организациях города и около 60% объектов питания в образовании, в том числе школы, детские сады, ссузы и вузы", - продолжил он.
Руководитель департамента проинформировал, что в ходе контроля объектов питания в Астане выявлено более 270 недостоверных медицинских книжек. Эти лица были отстранены от работ, а материалы переданы в соответствующие госорганы.
Он также отметил, что с начала года в результате трёх случаев пищевых отравлений, связанных с объектами общепита, здравоохранения и образования, пострадали более 160 человек. Все эти три объекта относятся к субъектам частного предпринимательства и не проверялись санитарной службой последние два-три года.
"Все знаете, был мораторий, и потому они не проверялись. По всем фактам возбуждены уголовные дела по статье 304 части первой Уголовного кодекса Казахстана", - уточнил он.
Напомним, по сообщению ДВД Астаны, с 28 по 31 марта в медицинские учреждения города поступили 22 человека с диагнозом "сальмонеллёз". Комитет по защите прав потребителей МНЗ РК подтвердил массовую сальмонеллёзную пищевую интоксикацию в Астане с 30 марта по 3 апреля. Всего за медицинской помощью обратился 31 человек. Пострадавшие были госпитализированы.
Лабораторное исследование выявило у повара и двух официантов ресторана, а также в готовых блюдах и полуфабрикатах бактериальные кишечные палочки. Как сообщила пресс-служба столичной полиции, с учётом совокупности собранных доказательств шеф-повару данного ресторана объявлено постановление о квалификации деяния подозреваемого по статье 304 часть 1 УК РК.
-
1💬 Казахстанцев предупредили о возможных фейках после окончания референдума
-
4560
-
2
-
45
-
-
2🍎 Сельхозярмарки в Алматы: где закупиться 14–15 марта
-
3455
-
0
-
12
-
-
3⚠️ Доброе утро, друзья! Предлагаем обзор главных новостей за 13 марта
-
3294
-
0
-
5
-
-
4🌤 Прогноз погоды на 16 марта: переменная облачность сохранится в регионах Казахстана
-
2970
-
0
-
9
-
-
5📲 "Соцсети запрещены, выходить могут". Об условиях домашнего ареста Жанабыловых рассказала адвокат
-
2972
-
1
-
25
-
-
6🍺 Минздрав предлагает изменить правила проверок казахстанцев на опьянение
-
2765
-
5
-
54
-
-
7⚽️ Матч "Кайрат" – "Актобе" в Алматы: полиция предупредила болельщиков
-
2649
-
1
-
20
-
-
8🗣️Отныне 15 марта мы будем ежегодно отмечать в качестве Дня Конституции🗣️ – Токаев
-
2494
-
11
-
169
-
-
9⚠️ Доброе утро, друзья! Предлагаем обзор главных новостей за 15 марта
-
2659
-
0
-
3
-
-
10📈 Вот такие данные по явке в конце дня опубликовали в Центральной избирательной комиссии
-
2831
-
4
-
50
-
 USD:
483.7 / 486.7
USD:
483.7 / 486.7
 EUR:
554.5 / 559.5
EUR:
554.5 / 559.5
 RUB:
5.95 / 6.09
RUB:
5.95 / 6.09


Комментарии
Пока нет комментариев…